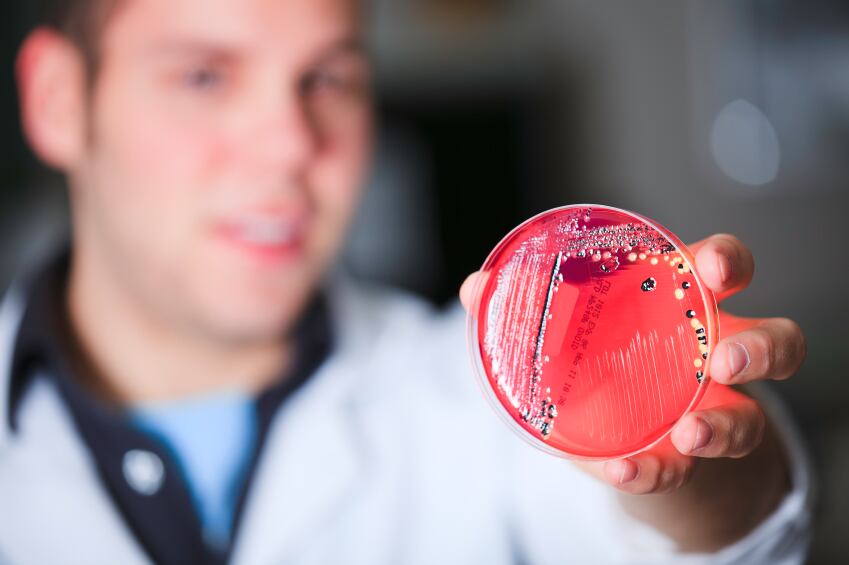
WATCH: How is microbiome science impacting the trend for personalisation?

Editor's Spotlight: Video Diary
WATCH: How is microbiome science impacting the trend for personalisation?
With a growing focus on the microbiome, and huge industry buzz about the potential for a new wave of personalised nutrition solutions, the NutraIngredients team asked experts at our recent Probiota conference how they think microbiome science and...
















